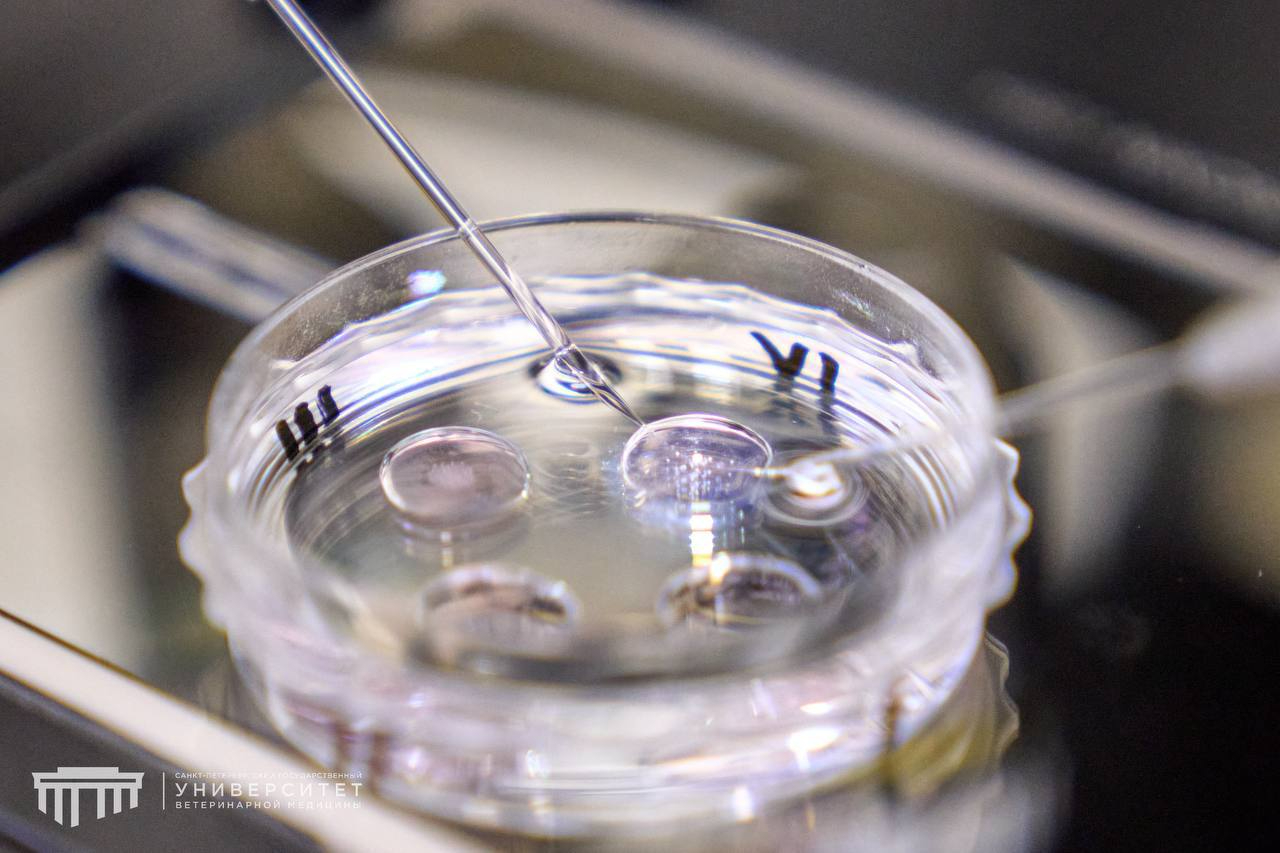

В Петербурге теленок выиграл генетическую лотерею
Специалисты СПбГУВМ совместно с аграриями племзавода "Бугры" вывели в лаборатории теленка. Малыш получен методом экстракорпорального оплодотворения (IVP).
Отец теленка — геномно-оцененный бык голштинской породы "Баркип" из США с TPI 3490, один из самых высоких показателей племенной ценности в мире. Мать — высокопродуктивная корова из Ленинградской области с удоем более 14 000 кг за 305 дней лактации.
Процесс включал оценку качества ооцита, его дозревание, оплодотворение, культивирование эмбриона 6–7 дней, криоконсервацию, подсадку корове-реципиенту и рождение через 278 дней. Метод IVP ускоряет селекцию до 40% и используется студентами и аспирантами университета.
В настоящее время средний удой в Ленинградской области вырос с 4–5 тыс. кг в 1980-е годы до 10 600 кг. 47 регион лидирует в России по продуктивности.
Ректор СПбГУВМ Кирилл Племяшов подчеркнул, что такой результат — это многолетний труд специалистов и вклад в развитие сельского хозяйства страны. Ветеринарная медицина важна не только для лечения животных, но и для будущего отрасли.

Фото: https://t.me/spbguvm_media/3384
